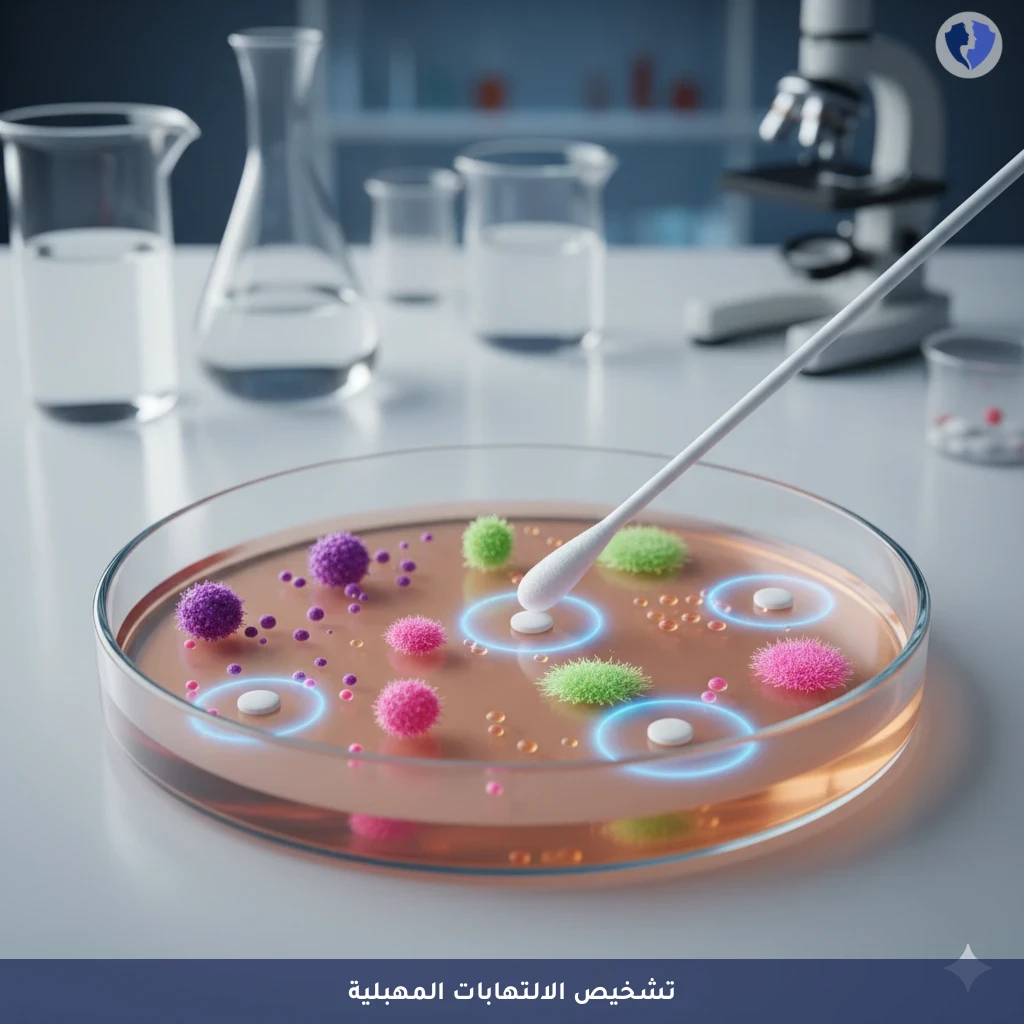
مزرعة مسحة مهبلية شاملة - مزرعة وحساسية مسحة المهبل العلوية (HVS)

تفاصيل الخدمة
مزرعة مسحة مهبلية شاملة - مزرعة وحساسية مسحة المهبل العلوية (HVS)
فحص ميكروبيولوجي يتم فيه زراعة عينة مأخوذة من الجزء العلوي من المهبل (High Vaginal Swab) على أوساط زرعية متنوعة (للجراثيم الهوائية، اللاهوائية، والفطريات). يهدف إلى عزل وتحديد الكائنات الدقيقة الممرضة أو المفرطة النمو (مثل بكتيريا Gardnerella vaginalis، Candida spp.، Trichomonas vaginalis أحياناً بطرق خاصة) التي تسبب التهاب المهبل. يتضمن الاختبار تحديد الحساسية للمضادات الحيوية/المضادات الفطرية (Antimicrobial Susceptibility Testing) لتوجيه العلاج الأمثل.